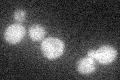
YDR400W
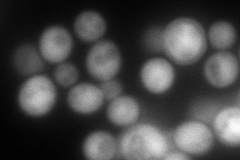
YDR400W
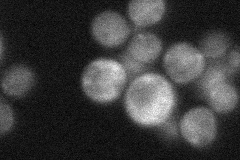
YDR400W

View description
Uridine nucleosidase (uridine-cytidine N-ribohydrolase), cleaves N-glycosidic bonds in nucleosides; involved in the pyrimidine salvage and nicotinamide riboside salvage pathways
Localization:
Intensity:
Fold change:
Significance:
-
C’ GFP library in SD
below threshold18.25 -
N' NOP1pr-GFP in SD

cytosol131.112 -
N' TEF2pr-mCherry in SD
cytosol202.779 -
N' NATIVEpr-GFP in SD
cytosol31.2376 -
N' TEF2pr-VC and Cyto-VN in SD

cytosol67.2111 -
C’ GFP library in SD+DTT

cytosol16.690.91No -
C’ GFP library in SD+H2O2

cytosol17.380.95No -
C’ GFP library in Starvation Media

cytosol29.561.61No -
C’ GFP library on the background of Pup2-DaMP

below threshold -
C’ GFP library on the background of CCT mutant

below threshold18.19110.996108No
